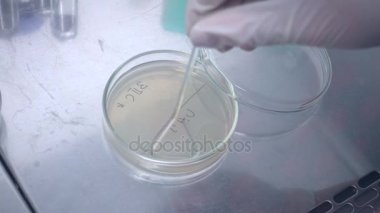
Laboratuvarda deneme. Örnek seçimi. Mikrobiyolojik laboratuvar çalışma. Bakterilerin bir petri üzerinde büyük bir yük bitki.

İhlal Bildirim Formu
En Çok Aranan Kelimeler
tabloArkaplandizayndonanımTutuluyorstüdyogiysidetayhobiDesenYaratıcılıkBiçimKumaşmodasanayiKadınÖlçprofesyonelYapÇizimKalemmalzemeTekstilimalatmeslekkılavuzDikişyapımı.Tasarımcıişyeriörgü işiİşlemzanaatMinimalizmişiTerziTerzi.terzilikatölyeBoşluğu kopyalaDikiş makinesiDişi Ellermilimetre kağıtsantimetre bantkumaş deseni binaBenzer İçerikler